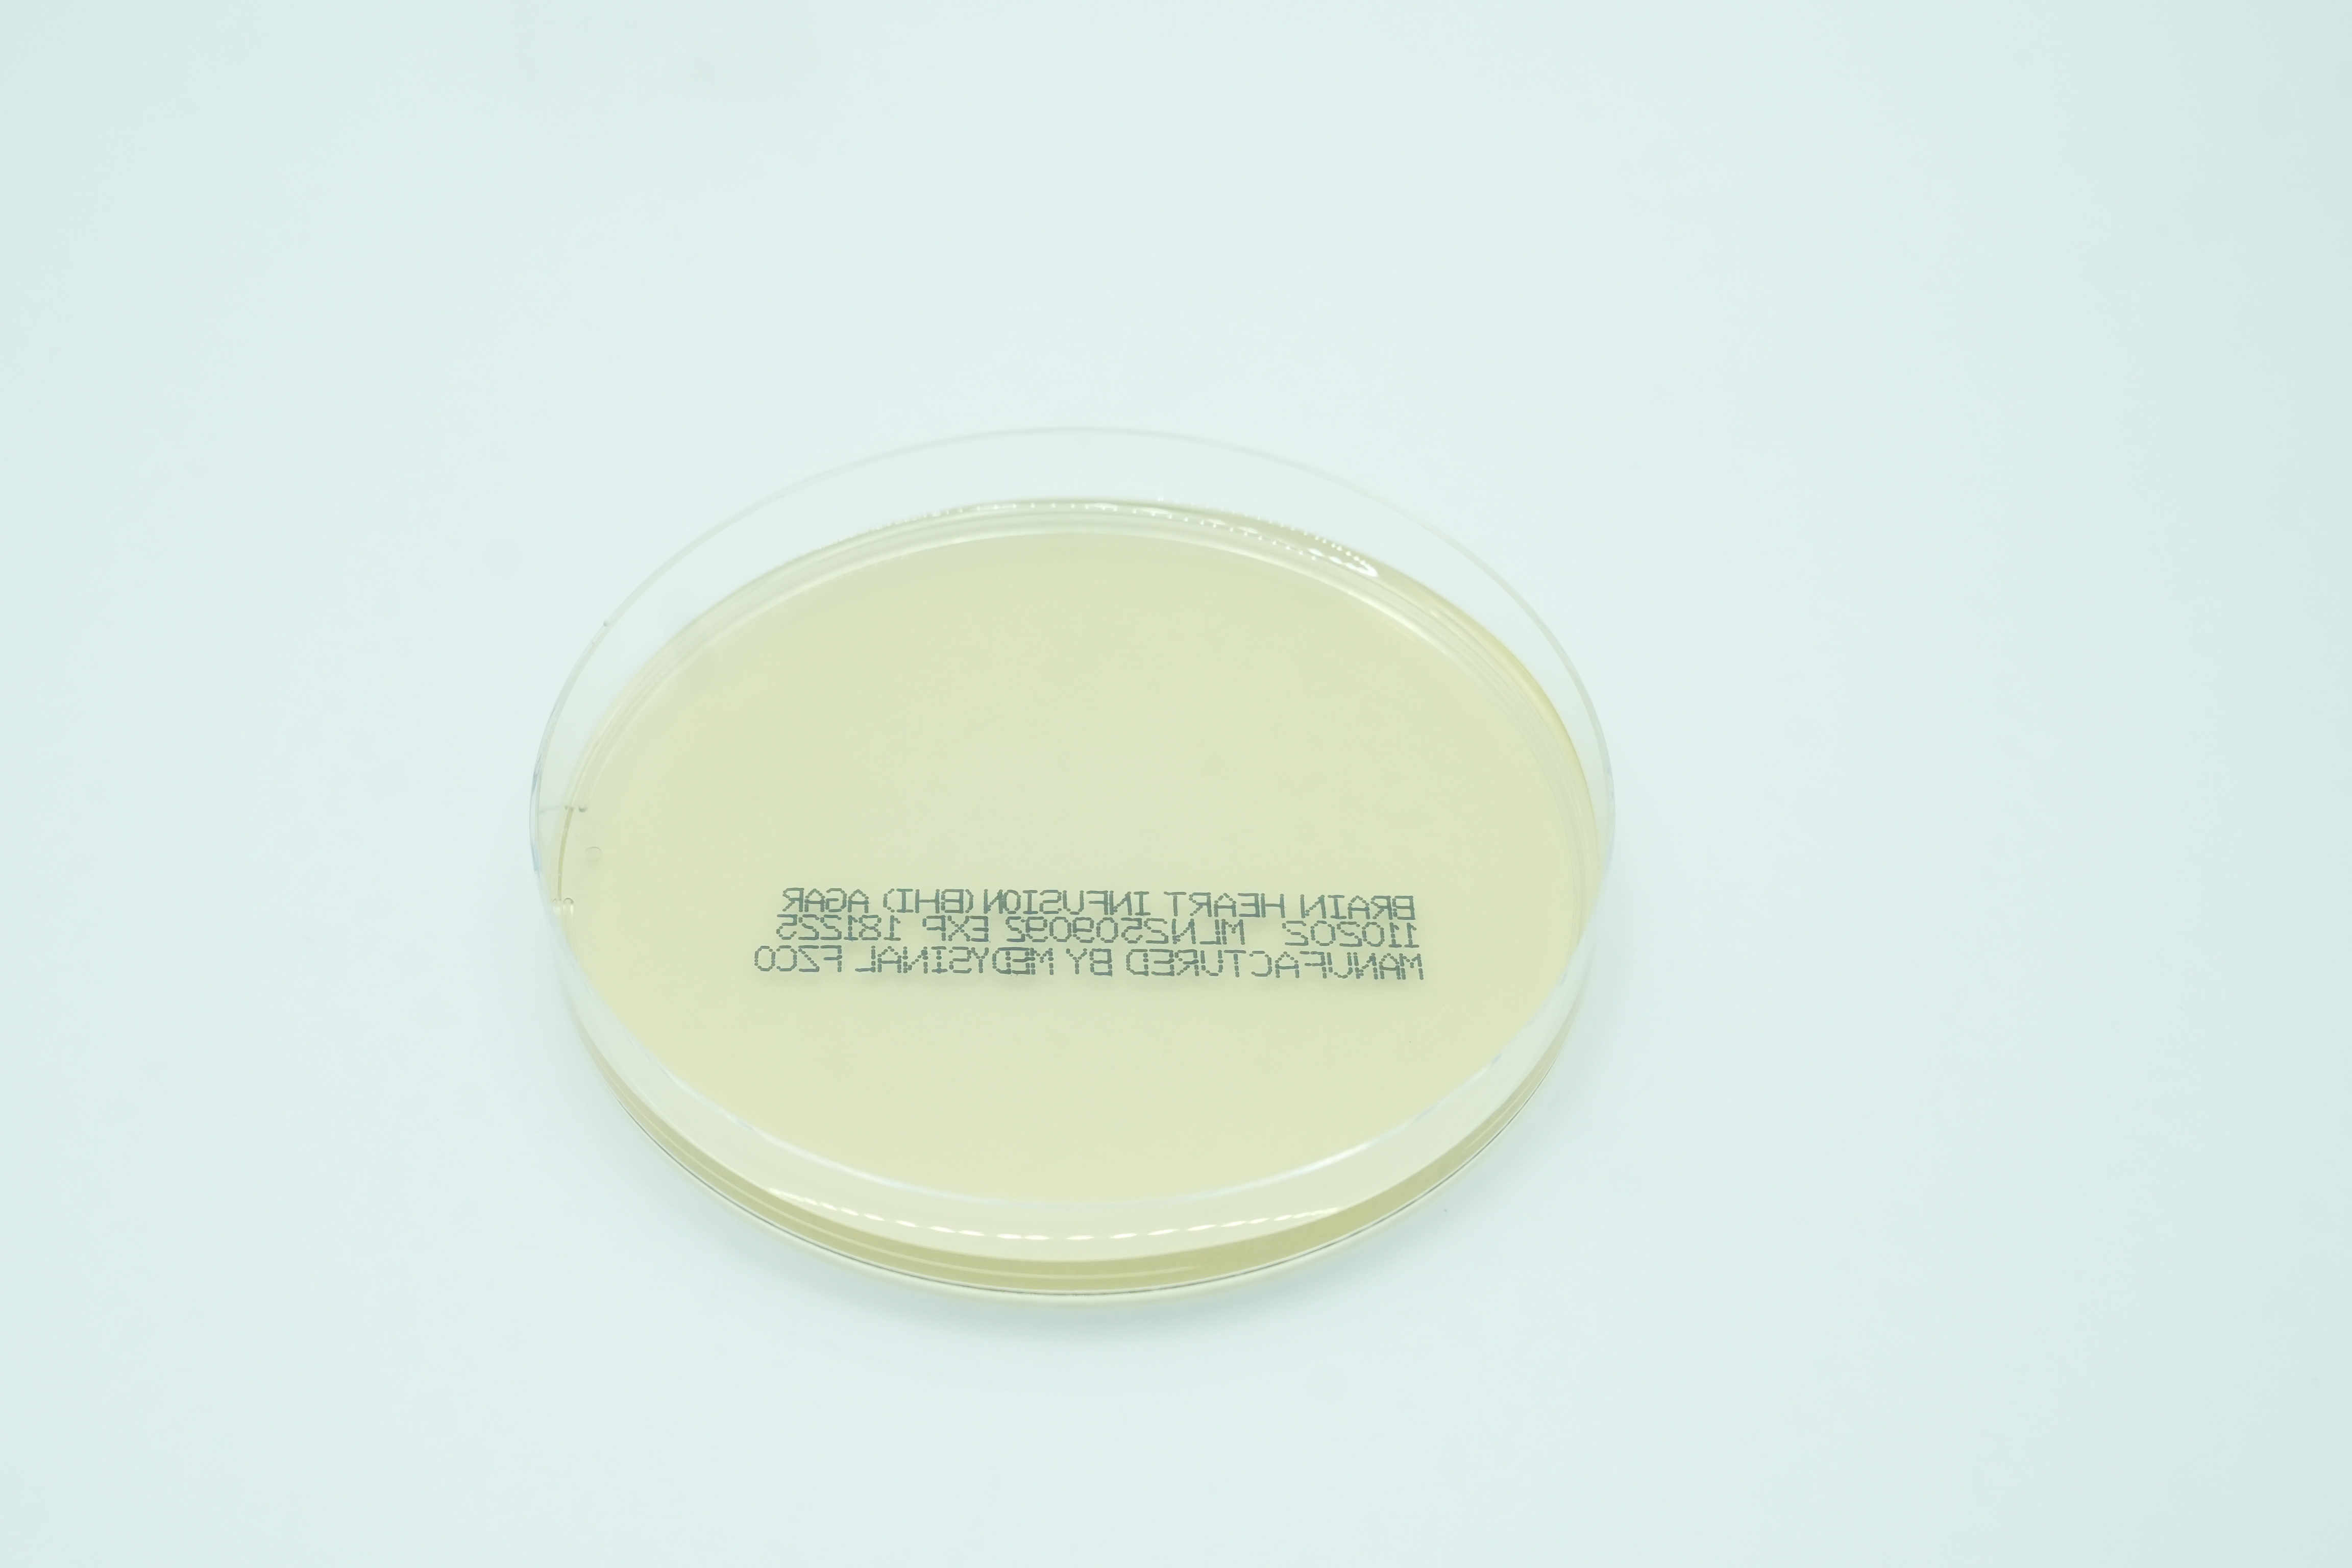

Thank you for your interest We will reach out to you

Oops! Something went wrong while submitting the form.
.svg)
Find a Product
Thank you! Your submission has been received!
Oops! Something went wrong while submitting the form.

Decolorizer - TB fluoroscent Kit
1015

Listeria Agar 90MM
110234

CHROMagar VRE
110326

Sab Dex w Gentamicin& Chloramphenicol
111910

Selectrol® Raoultella planticola NCTC® 9528 formerly Klebsiella aerogenes

Selectrol® Escherichia coli NCTC® 11954 / ATCC® 35218

Selectrol® Escherichia coli NCTC® 11560

Sabouraud Dextrose Agar / Mycosel Agar
120107

Columbia Agar
110311

Urea Agar Slants
4321096

SABHI Agar w Gentamicin & Chloramphenicol
111918

Sabouraud Dextrose Agar Slants
4321012

MRS Agar 90MM
110235

Mueller Hinton Agar
111305

Mueller Hinton Agar w 2% NaCl
111317

Selectrol® Klebsiella pneumoniae (CRE) NCTC® 13438

Bile Esculin Azide Agar
110221

Selectrol® Pseudomonas paraeruginosa NCTC® 12924 / ATCC® 9027

Chromogenic Candida
110314

Hektoen Enteric Agar
110801

Sab. Dex Agar with Chloremphenicol
111909

Selectrol® Campylobacter jejuni NCTC® 11351 / ATCC® 33560

Oxytetracycline Glucose Yeast Agar 90MM
110237

Selectrol® Rhodococcus hoagii NCTC® 1621 / ATCC® 6939

Triple Sugar Iron Slant
4321038

Nutrient Agar Slants
421001

Yeast glucose chloramphenicol agar 90MM
110239

Martin Lewis Agar
111304

Sterile Water 5ml
412003

Selectrol® Listeria innocua NCTC® 11288 / ATCC® 33090

Selectrol® Listeria monocytogenes NCTC® 7973 / ATCC® 35152

MacConkey w/o Crystal Violet
111302

Sabouraud Dextrose Agar w Cycloheximide
111912

Selectrol® Enterococcus faecalis NCTC® 12697 / ATCC® 29212

Carbolfuchsin Stain-ZN Acid Fast Stain
1008

Trypticase Soy Broth 9ml
4321716

Loweinstein-Jensen (LJ) Slants
4321387

Medygraine 100Mg
110103
%201.png)
G. Vaginalis Sel. Medium (V Agar)
110701

Selectrol® Bacillus cereus NCTC® 7464 / ATCC® 10876

MYP (Mannitol Egg Yolk Poymyxin) Agar 90MM
110231

Mueller Hinton Agar 150
211305

CHROMagar Staph aureus
110331

Chocolate Agar 150
211303

Diabetica Wallet Organizer
110204

MacConkey Agar CS
111313

Selectrol® Escherichia coli NCTC® 10418 / ATCC® 10536

Corn Meal Agar
110310

Selectrol® Saccharomyces cerevisiae NCPF® 3178

Gram's safranin O
1004

Selectrol® Staphylococcus aureus NCTC® 12493

Dermatophyte Agar
110405

Trypticase Soy with Lecithin and Polysorbate 80
112006

Selectrol® Escherichia coli NCTC® 12241 / ATCC® 25922

Novuhair
110107

Xylose Lysine Desoxycholate (XLD)Agar
112401

CHROM Campylobacter Agar
110338

Selectrol® Salmonella Poona NCTC® 4840

Eosin Methylene Blue (EMB) Agar
110501

Selectrol® Listeria monocytogenes NCTC® 10527 / ATCC® 13932

Selectrol® Streptococcus pneumoniae NCTC® 12695 /ATCC® 6303

TE Buffer
NA

Auramine-Rhodamin - TB fluoroscent Kit
1014
%201.png)
Mueller Hinton Broth (5 ml)
4397220

Selectrol® Klebsiella pneumoniae (CRE) NCTC® 13442

Selectrol® Klebsiella pneumoniae NCTC® 9633 / ATCC® 13883

Nutrient Broth, 5 ml
4321669

Selectrol® Enterococcus faecalis NCTC® 12697 / ATCC® 29212

Selectrol® Bacillus subtilis subsp spizizenii NCTC® 10400 / ATCC® 6633

Selectrol® Bacteroides fragilis NCTC® 9343 / ATCC® 25285

Lim Broth
412001

Mueller Hinton Blood Agar
111306

Sheep Blood Agar / Chocolate Agar
120403

Selectrol® Candida tropicalis NCPF® 3111

Selectrol® Neisseria gonorrhoeae NCTC® 8375 / ATCC® 19424

SABHI Agar
111913

Rappaport Broth
418001

Bile Esculin Agar Slants
4321813

Bacteroides Bile Esculin (BBE) Agar
110223

BCYE Selective Agar
110217

Selectrol® Staphylococcus aureus NCTC® 12981 / ATCC® 25923

CHROMagar Orientation
110328

Columbia CNA Blood Agar/MacConkey Agar Biplate
120413

MSRV Agar 90MM
110236

CHROMagar Y.enterocolitica
110332

Nutrient Agar
111402

MEDYFAST-RT H. Pylori Kit 20 tests
511505

Selectrol® Staphylococcus aureus NCTC® 10788 / ATCC® 6538

Legionella BCYE Selective Agar 60MM
113003

Selectrol® Escherichia coli NCTC® 12923 / ATCC® 8739

Fluid Thioglycolate Medium
4390641

Selectrol® Salmonella Enteritidis NCTC ® 12694 / ATCC® 13076

MFC (M Fecal Coliform) Agar 90MM
110230

Mueller Hinton Chocolate agar
111309

Trypticase Soy Agar
112002

Selectrol® Escherichia coli (mcr-1) NCTC® 13846

Pseudosel Agar
351603

Selectrol® Acinetobacter baumannii NCTC® 12156 / ATCC® 19606

Trypticase Soy Agar with Lecithin and Polysorbate 80, Rodac Plates
112010

Methicillin Resistant S. aureus (MRSA) Agar
111308
.svg)

%20Broth%2C%205%20ml%201.png)











.svg)